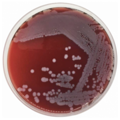
E-shop hlavní obrázek

Diagnostická souprava určená pro detekci karbapenemáz; KPC a MBL u Enterobacteriaceae.
Kultivační půda pro izolaci, kultivaci a detekci hemolytické aktivity náročných organismů. Tento produkt je dodáván v dehydratované formě a je určen pro přípravu hotových kultivačních médií.

Krevní agar / ENDO v kultivačních destičkách se používá k identifikaci patogenů hlavně z močových cest.

Krevní agar / MacConkey agar v se používá k identifikaci patogenů hlavně z močových cest.

Krevní agar s NaCl se používá jako selektivní medium pro stafylokoky.

Agarové médium Columbia s ovčí krví doplněné inhibiční směsí (kolistin + kyselina oxolinová + amphotericin) je selektivní médium pro streptokoky. Používá se rovněž k průkazu hemolytických reakcí. Médium se používá pro analýzu směsných vzorků bakteriální flóry, například vzorků z genitálního traktu.

Krevní agar (Columbia agar + 5% beraní krev) se používá jako médium k primokultivaci nebo subkultivaci pro všechny typy vzorků. Přítomnost krve umožňuje prokázat hemolytické reakce určitých kmenů bakterií. Uriselect - neselektivní chromogenní agar pro izolaci, stanovení počtu a identifikaci bakteriálních patogenů močových cest. Umožňuje přímou identifikaci E.coli, Enterococcus sp. a Proteus sp. a presumptivní identifikaci skupiny KES (Klebsiella sp., Enterobacter sp. a Serratia sp.)

Barvící roztok pro Gramovo barvení.

Kultivační půda vhodná pro produkci chlamydospór Candida albicans a pro kultivaci fytopatologických hub. Tento produkt je dodáván v dehydratované formě a je určen pro přípravu hotových kultivačních médií.

Hydrolyzát kyseliny kaseinové používaný jako složka kultivačních médií.

Testovací proužky LabStrip U mALB/CREA

AESKULISA Lactoferrin je enzymoimuno-analytická souprava pro kvantitativní a kvalitativní detekci protilátek proti laktoferrinu v lidském séru, využívající nativní lidský laktoferrin.

Diatabs™ identifikační tablety určené ke kvalitativní detekci mikrobiálních charakteristik při identifikaci mikroorganismů.

CE IVD certifikovaný diagnostický kit pro detekci mutací způsobujících laktózovou intoleranci.

Barvivo používané k identifikaci hub a plísní v připravených sklíčkách z klinických vzorků.

Selektivní médium pro potvrzení Clostridium perfrongens.
Produkt je dodáván v dehydratované formě a je určen pro přípravu hotových kultivačních médií.

Selektivní médium pro detekci koliformních bakterií a předběžné obohacení salmonel.
Tento produkt je dodáván v dehydratované formě a je určen pro přípravu hotových kultivačních médií.

LAL enzymatická metoda je určena na stanovení v různých biologických tekutinách včetně séra. Je dodávána v balení po 3 destičkách, tj. 3 x 96 jamek.